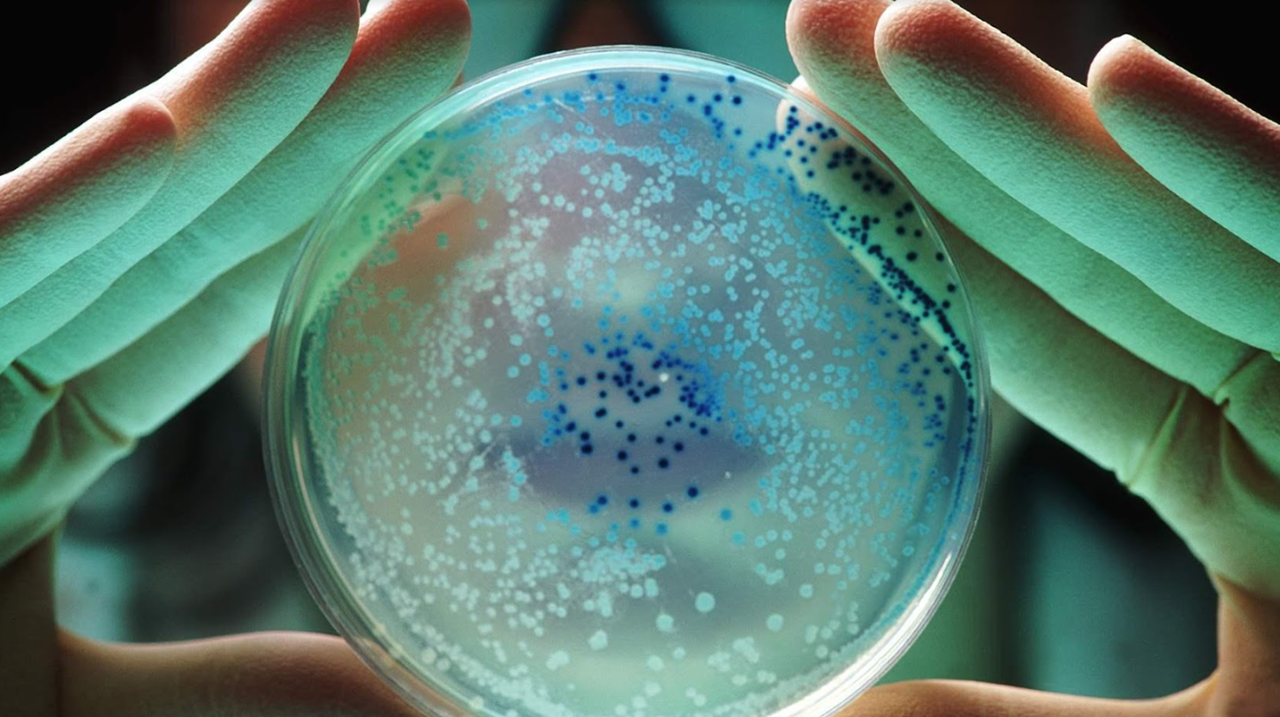

Σύνταξη – επιμέλεια: Στέλιος Βασιλούδης
Η γεωργία, τα φαρμακευτικά προϊόντα και η ρύπανση από τα απόβλητα του τομέα υγείας τροφοδοτούν την αύξηση των υπερμικροβίων, προειδοποιεί ο ΟΗΕ
Τα λύματα, η κακή υγιεινή και η έλλειψη ρύθμισης προκαλούν μικροβιακή αντοχή και απειλούν την παγκόσμια υγεία, αναφέρει η έκθεση. Συγκεκριμένα, η ρύπανση από την κτηνοτροφία, τα φαρμακευτικά προϊόντα και την υγειονομική περίθαλψη απειλεί να καταστρέψει έναν βασικό πυλώνα της σύγχρονης ιατρικής, καθώς οι διαρροές κοπριάς και άλλη ρύπανση σε υδάτινες οδούς προσθέτουν στην παγκόσμια αύξηση των υπερμικροβίων.
Η εκτροφή ζώων είναι μια από τις βασικές πηγές στελεχών βακτηρίων που έχουν αναπτύξει αντοχή σε όλες τις μορφές αντιβιοτικών, μέσω της υπερβολικής χρήσης των φαρμάκων στη γεωργία. Η φαρμακευτική ρύπανση των υδάτινων οδών, από εργοστάσια παραγωγής φαρμάκων, συμβάλλει επίσης σε μεγάλο βαθμό, σε συνδυασμό με την αποτυχία παροχής αποχέτευσης και ελέγχου των λυμάτων σε όλο τον κόσμο και την αντιμετώπιση των απορριμμάτων από τις εγκαταστάσεις υγειονομικής περίθαλψης. Τα ανθεκτικά υπερβακτήρια μπορούν να επιβιώσουν σε μη επεξεργασμένα λύματα.
Τα ευρήματα της νέας έκθεσης, που δημοσιεύθηκε πρόσφατα, δείχνουν ότι η ρύπανση και η έλλειψη υγιεινής στον αναπτυσσόμενο κόσμο δεν μπορούν πλέον να θεωρούνται από τον πλούσιο κόσμο ως ένα μακρινό και τοπικό πρόβλημα για τους φτωχούς, αποκλειστικά. Όταν εμφανίζονται τα υπερμικροβακτηρια, εξαπλώνονται γρήγορα και απειλούν την υγεία ακόμη και των ανθρώπων σε καλά χρηματοδοτούμενα συστήματα υγειονομικής περίθαλψης στον πλούσιο κόσμο.

Η κακή υγιεινή και υγειονομική περίθαλψη, καθώς και η έλλειψη κανονισμών στην κτηνοτροφία, δημιουργούν έδαφος αναπαραγωγής ανθεκτικών βακτηρίων και ως αποτέλεσμα, απειλούν την παγκόσμια υγεία, σύμφωνα με το Περιβαλλοντικό Πρόγραμμα του ΟΗΕ στην έκθεση. Έως και 10 εκατομμύρια άνθρωποι ετησίως θα μπορούσαν να πεθαίνουν μέχρι το 2050 – ως αποτέλεσμα της μικροβιακής αντοχής (Antibiotic Microbial Resistance – AMR), σύμφωνα με τον ΟΗΕ, γεγονός που την καθιστά τόσο μεγάλο δολοφόνο όσο ο καρκίνος σήμερα.
Η αύξηση των υπερμικροβίων θα έχει επίσης οικονομικό τίμημα, με αποτέλεσμα την απώλεια περίπου 3,4 τρις δολ. ετησίως μέχρι το τέλος αυτής της δεκαετίας και την ώθηση 24 εκατομμυρίων ανθρώπων στην ακραία φτώχεια.
Η Inger Andersen, εκτελεστική διευθύντρια του UNEP, δήλωσε: «Η ρύπανση του αέρα, του εδάφους και των υδάτινων οδών υπονομεύει το ανθρώπινο δικαίωμα σε ένα καθαρό και υγιές περιβάλλον. Οι ίδιοι παράγοντες που προκαλούν περιβαλλοντική υποβάθμιση επιδεινώνουν το πρόβλημα της μικροβιακής αντοχής, οι επιπτώσεις της οποίας θα μπορούσαν να καταστρέψουν τα συστήματα υγείας και διατροφής μας». Η ίδια ζήτησε επείγουσα δράση για να σταματήσει η ρύπανση. «Η μείωση της ρύπανσης είναι προϋπόθεση για έναν ακόμη αιώνα προόδου προς τη μηδενική πείνα και την καλή υγεία», δήλωσε κατά την παρουσίαση της έκθεσης στην έκτη συνάντηση της Global Leaders Group για την AMR στα Μπαρμπάντος. Η έκθεση διαπίστωσε ότι τα λύματα, οι κακές εγκαταστάσεις υγιεινής και η ανεπαρκής διαχείριση των απορριμμάτων συνέβαλαν στο πρόβλημα.
Ο Simon Clarke, μικροβιολόγος στο Πανεπιστήμιο του Ρέντινγκ, ο οποίος δεν συμμετείχε στην έκθεση, είπε ότι οι άνθρωποι αποτυγχάνουν συχνά να αναγνωρίσουν πόσο μεγάλη διαφορά είχε κάνει η χρήση αντιβιοτικών στη σύγχρονη ιατρική. «Λόγω της αποτελεσματικότητας των αντιβιοτικών, ίσως έχουμε ξεχάσει τον θανατηφόρο αντίκτυπο που είχαν πολλές λοιμώξεις στο παρελθόν. Ο κίνδυνος του να μην κάνουμε τίποτα τώρα είναι ότι, κάθε τραυματισμός, εγχείρηση ή επίσκεψη ρουτίνας στο νοσοκομείο ενέχει τον κίνδυνο να κολλήσει κανείς μια θανατηφόρα λοίμωξη», συμπλήρωσε.
.png)
Τα υπερμικρόβια έχουν συσχετιστεί στο παρελθόν με νοσοκομειακές λοιμώξεις, όπως το MRSA (Methicillin Resistant Staphylococcus Aureus). Όμως, αυτό αλλάζει, προειδοποίησε ο Oliver Jones, καθηγητής χημείας στο Πανεπιστήμιο RMIT της Μελβούρνης. «Τείνουμε να θεωρούμε ότι η βακτηριακή αντίσταση είναι ένα πρόβλημα που σχετίζεται με τα νοσοκομεία. Αυτό που δείχνει αυτή η έκθεση είναι ότι τα αντιβιοτικά και άλλα φάρμακα που καταλήγουν στο περιβάλλον είναι ένας σημαντικός παράγοντας για τη διάδοση της αντοχής στα αντιβιοτικά και κάτι στο οποίο πρέπει να δώσουμε προσοχή νωρίτερα παρά αργότερα», είπε.
Οι κυβερνήσεις και οι επενδυτές του ιδιωτικού τομέα στον ανεπτυγμένο κόσμο θα πρέπει να αφυπνιστούν για τους κινδύνους και να παράσχουν τους πόρους για την αντιμετώπιση της ρύπανσης στον αναπτυσσόμενο κόσμο, κάτι που θα ήταν προς το δικό τους συμφέρον, προτείνει η έκθεση.
Η γεωργία πρέπει επίσης να είναι βασικός στόχος, πρόσθεσε ο Matthew Upton, καθηγητής ιατρικής μικροβιολογίας στο Πανεπιστήμιο του Πλύμουθ. «Αν και η κατάσταση βελτιώνεται σε ορισμένα μέρη του κόσμου, τεράστιες ποσότητες αντιμικροβιακών χρησιμοποιούνται για τη θεραπεία και την πρόληψη λοιμώξεων αλλά και την πάχυνση σε εκτρεφόμενα ζώα. Η βελτίωση των μεθόδων εκτροφής και άλλες πρακτικές πρόληψης και ελέγχου των λοιμώξεων, όπως ο εμβολιασμός, θα πρέπει να χρησιμοποιούνται για τη μείωση των λοιμώξεων και της ανάγκης για χρήση αντιμικροβιακών φαρμάκων, η οποία με τη σειρά της θα περιορίσει τη ρύπανση του περιβάλλοντος με αντιμικροβιακά και τα υπολείμματα τους καθώς και τα ανθεκτικά μικρόβια. Αυτό ισχύει ιδιαίτερα στην υδατοκαλλιέργεια, η οποία θα είναι μια σημαντική πηγή υδρόβιων πρωτεϊνών έως το 2050», ανέφερε.
Η Catrin Moore, ανώτερη λέκτορας στο St George’s Hospital του Πανεπιστημίου του Λονδίνου, έκανε παραλληλισμούς με την αποτυχία των εταιρειών ύδρευσης και της κυβέρνησης του Ηνωμένου Βασιλείου να ελέγξουν την ευρεία απελευθέρωση λυμάτων σε ποτάμια και παραλίες. «Αυτή η αναφορά μου υπενθυμίζει ότι τα υψηλά επίπεδα AMR θα μπορούσαν τελικά να είναι στο κατώφλι μου και στο νερό που κολυμπώ – με ακατέργαστα ανθρώπινα απόβλητα να απελευθερώνονται σε τοπικές πλωτές οδούς», δήλωσε. «Αν και η υψηλότερη επιβάρυνση της AMR εντοπίζεται σε χώρες χαμηλού και μεσαίου εισοδήματος, τα ανθεκτικά βακτήρια μπορούν να εξαπλωθούν εύκολα – δεν σέβονται τα σύνορα χωρών. Σε τελική ανάλυση, αν αυξηθούν τα ανθεκτικά παθογόνα στο τοπικό μου περιβάλλον, η μείωση της θνησιμότητας και της νοσηρότητας λόγω AMR θα είναι αδύνατο έργο», κατέληξε.
Πηγή: The Guardian









